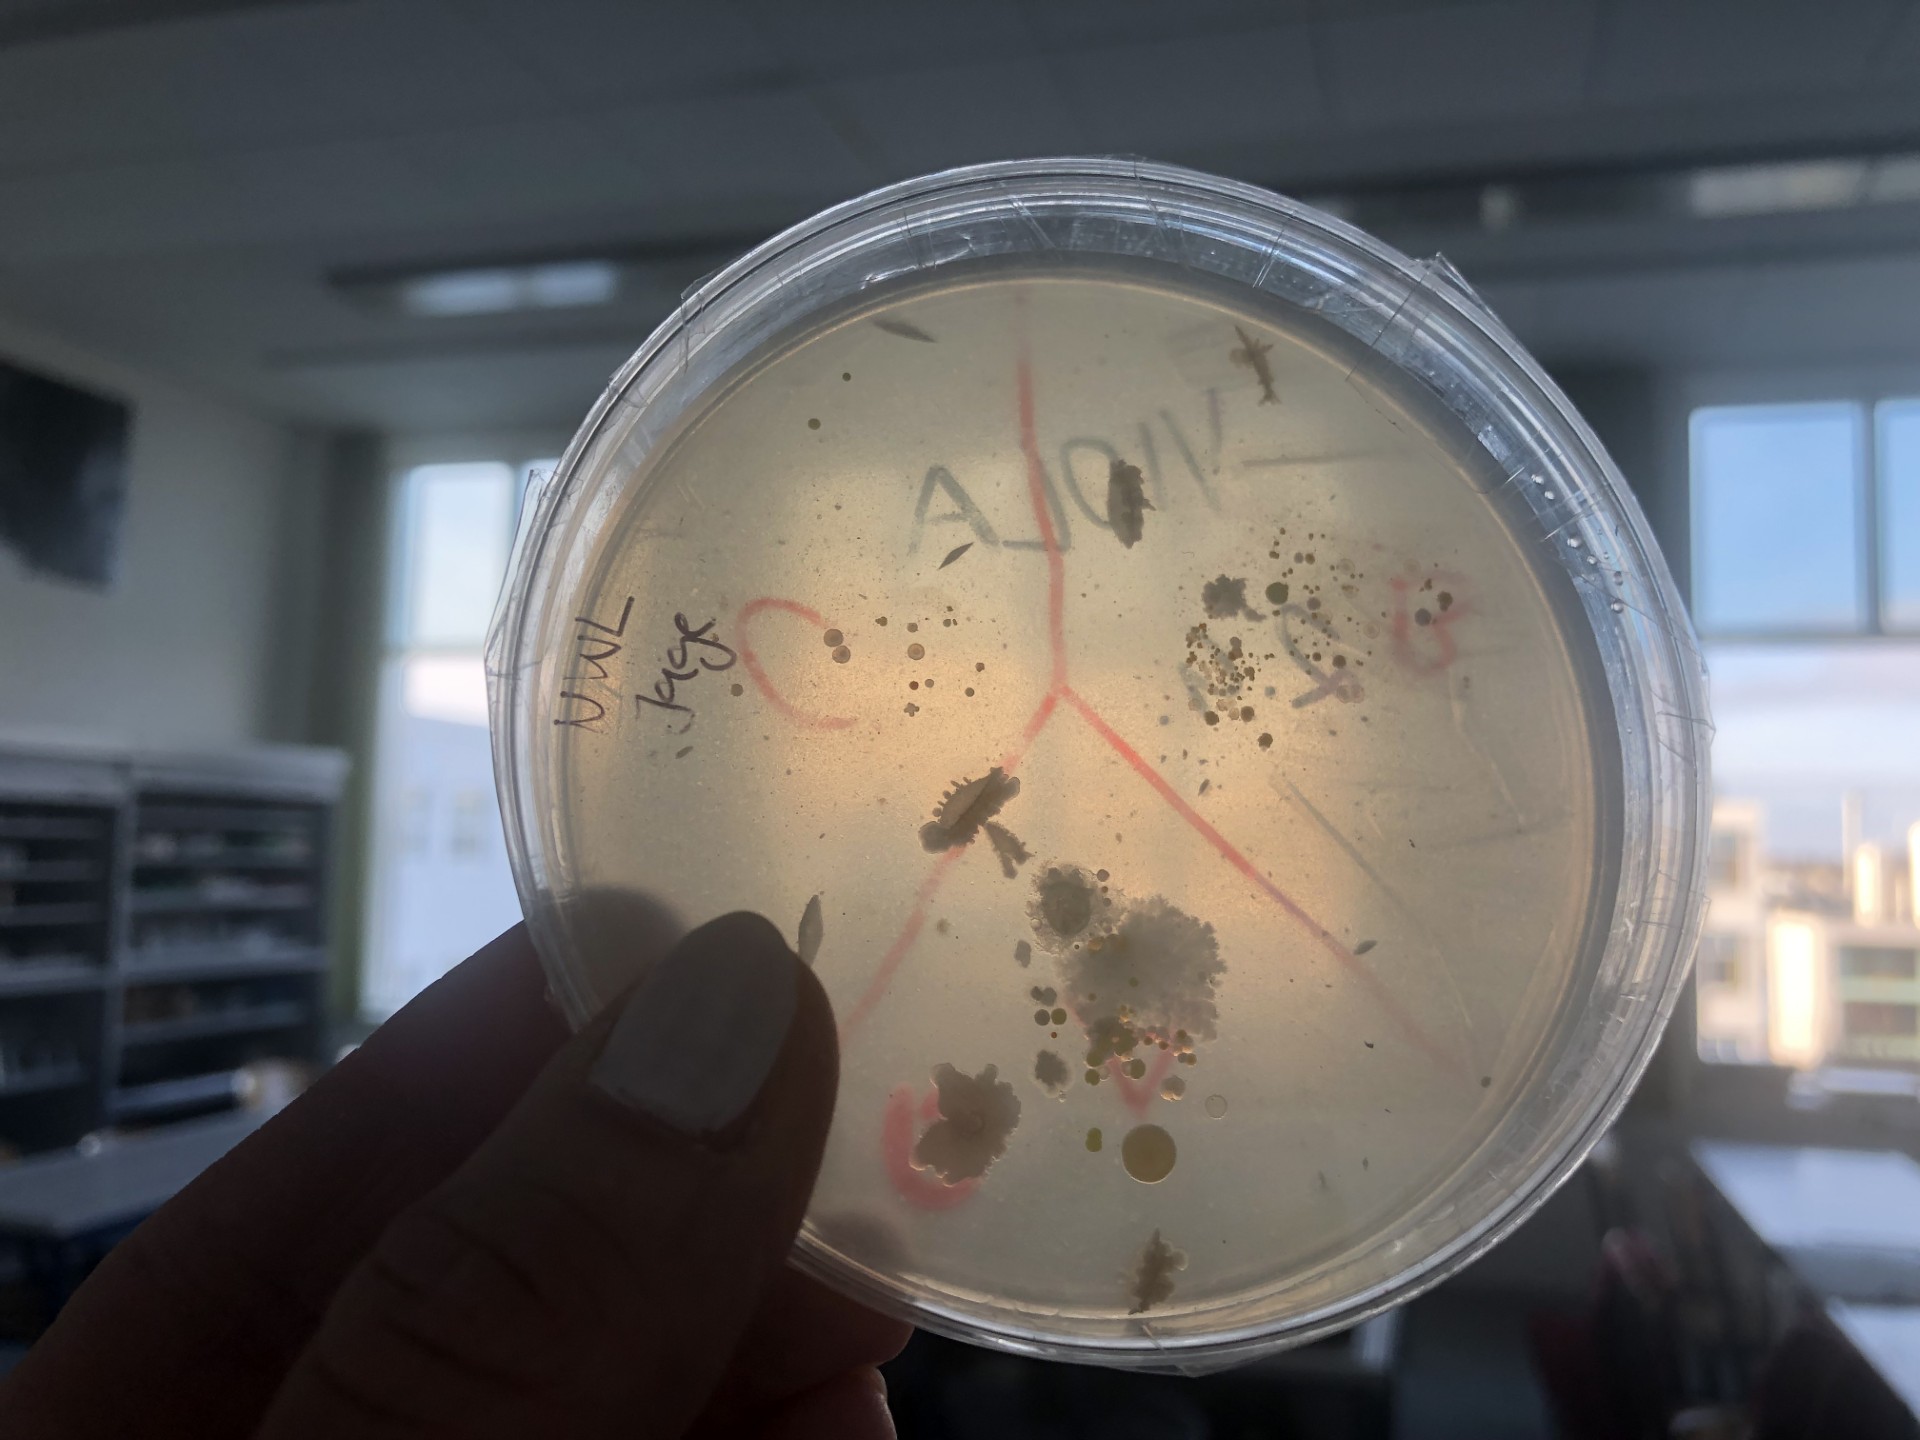

Wahlpflichtgegenstände (WPG)
In der 5. Klasse können sich die Schüler und Schülerinnen für Wahlpflichtgegenstände entscheiden, welche sie ab der 6. Klasse besuchen.
Im WRG wird über die Wahlpflichtgegenstände (WPG) entschieden, im ORG wird in der Regel die Wahl des kreativen oder naturwissenschaftlichen Zweiges mit der Wahl des entsprechenden Alternativen Pflichtgegenstandes (APG) bestätigt.